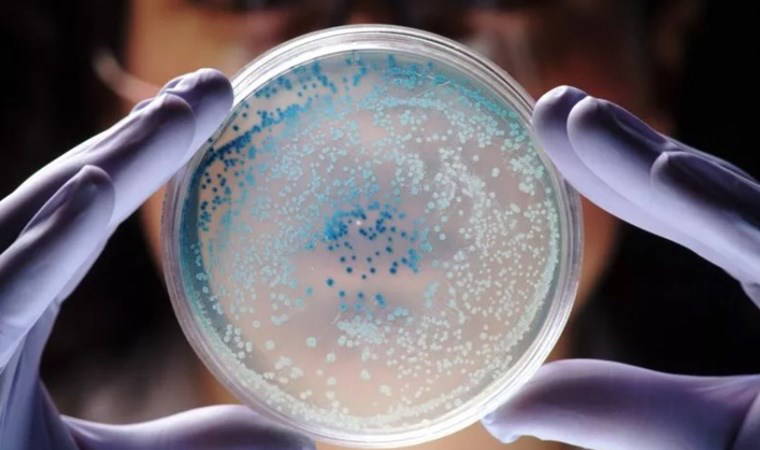

Hakemli bilimsel dergi Nature Microbiology'de yayınlanan yeni bir araştırmaya göre, cesetler mikrobiyal ağlar söz konusu olduğunda büyük benzerlikler gösteriyor.
Bağışlanan 36 ceset üzerinde teknik analizler yapan bilim insanları, tüm cesetlerde bulunan ve çürüme sürecinin belirli aşamalarında saat gibi işleyen 20 farklı mikroptan oluşan bir ağ keşfetti. Cesetler farklı çevresel özelliklere, farklı toprak türlerine sahip yerlere gömülmüş olsa da araştırmacılar tarafından alınan tüm örneklerde aynı mikrop seçkisinin olduğu görüldü.
Bilim insanları, bu keşfin cinayet soruşturmalarında, cesetlerin ölüm zamanını saptamak için kullanılabileceğini ve cinayetleri çözme çabalarına önemli ölçüde yardımcı olacağını umuyor.
KUSURSUZ SİSTEM
Colorado Eyalet Üniversitesi'nde mikrobiyoloji ve ekoloji doçenti olan makale yazarı Dr. Jessica Metcalf, basına yaptığı açıklamada, "Canlıların kalıntılarını ayrıştırmak için ortaya çıkan bu mikropların varlığının teyit edilmesi gerçekten harika. Umarım, ekolojik araştırmalarda yepyeni bir alan açıyoruzdur" dedi.
Newsweek'te yer alan habere göre, çalışma kapsamında, 36 kadavra incelendi ve mikrobiyomların, yılın farklı zamanlarında çürüme sırasında nasıl değiştiği ölçüldü.
Araştırmacılar, iklim ve toprak türünden bağımsız olarak, 36 cesedin tamamında aynı 20 mikrop kümesinin bulunduğunu ve bu mikropların, tüm cesetlerde aynı zamanda ortaya çıktığını tespit etti.
Metcalf, "Aklınıza gelebilecek her türlü dış mekan değişkeninden bağımsız olarak, ayrışma sırasında benzer mikropların benzer zamanlarda geldiğini görüyoruz" dedi.
CİNAYETLERİ AYDINLATACAK
Habere göre, bu bulgunun adli tıp bilimi açısından önemli sonuçları var, zira bu mikroplar, bir cesedin ne kadar süredir ölü olduğunu daha kesin bir şekilde anlamaya yardımcı olmak için kullanılabilir.
Zira çalışmadan elde edilen verileri kullanan yazarlar da ölümden bu yana geçen süreyi tahmin edebilen "mikrobiyoma dayalı bir sistem" geliştirmeyi başardı.
Öte yandan, Honolulu'daki Chaminade Üniversitesi'nde adli bilimler profesörü olan, makalenin ortak yazarı David Carter, basına yaptığı açıklamada şu ifadelere yer verdi:
"Ölüm olaylarını araştırmak söz konusu olduğunda; her olay yerinde bulunacağını garanti edebileceğiniz çok az fiziksel kanıt türü vardır. Parmak izi, kan lekesi ya da kamera görüntüsü her zaman mevcut olmayabilir, fakat mikroplar her zaman orada olacaktır..."
BÖCEKLER GETİRİYOR...
Bilim insanları, söz konusu mikropları cesetlere, beslenmek ve yumurtalarını bırakmak için gelen böcekler aracılığıyla getirildiğini öngörüyor.
Makalenin yazarı Dr. Jessica Metcalf da bu görüşü paylaşıyor.
Araştırmacılar bu bulguların sadece adli soruşturmalarda değil, mikrobiyal ekoloji araştırmaları ve tarımda da kullanılabileceğini umuyor.